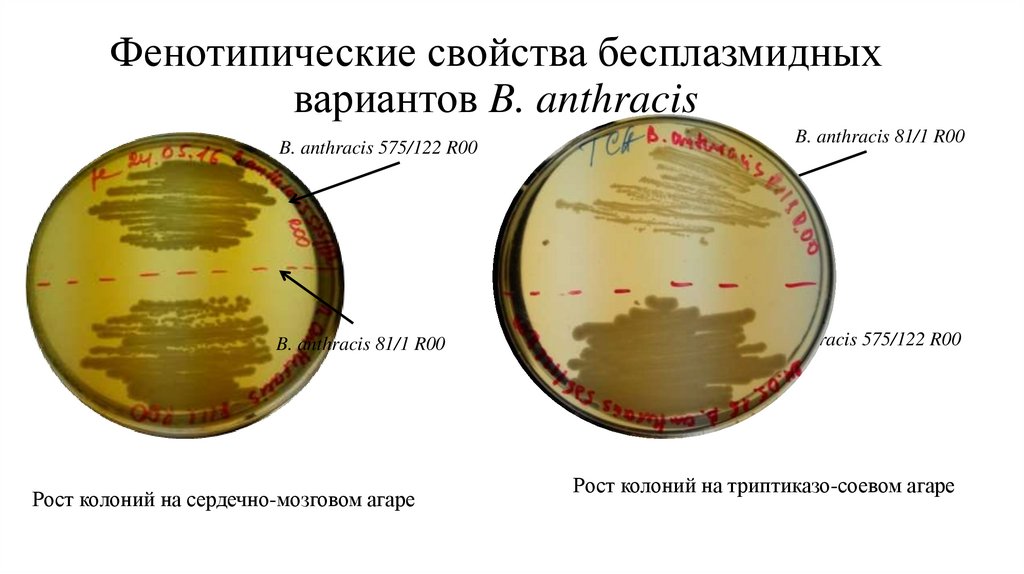
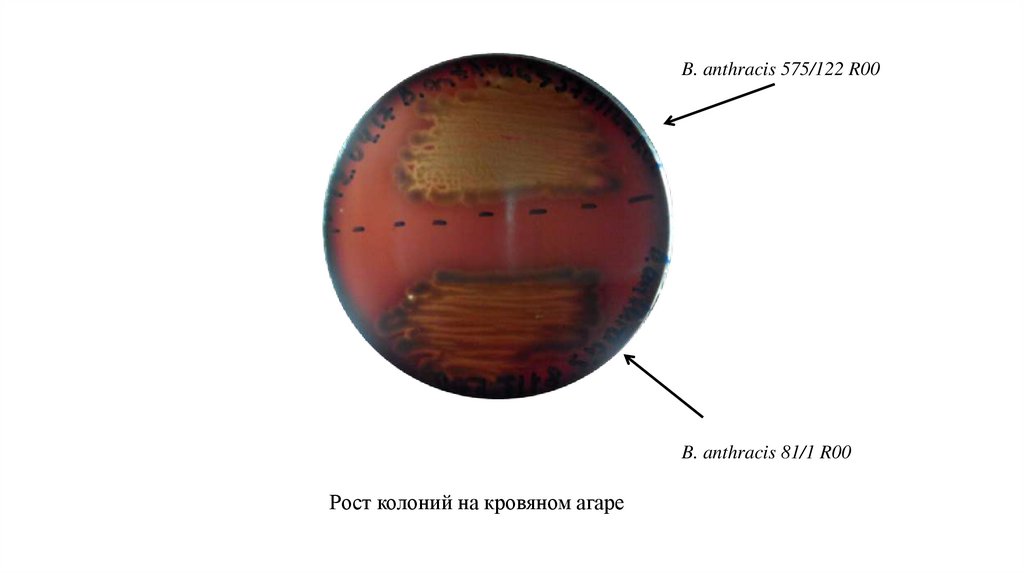

Similar presentations:
Сравнительный анализ молекулярно-генетических и фенотипических свойств изогенных штаммов в. anthracis
1.
Сравнительный анализ молекулярно-генетических ифенотипических свойств изогенных штаммов
B. anthracis
Ижбердеева М.П., Антонов А.С., Устинов Д.В., Баркова И.А., Шпак И.М.
2.
Сибирская язва - особо опасное инфекционноезаболевание
Bacillus anthracis
https://www.google.wikipedia.
3.
Плазмиды вирулентностиB. anthracis
Синтез капсулы
4.
Получение бесплазмидных вариантовB. anthracis
t 42, 50 С
в среде
с канамицином
B. anthracis 575/122
B. anthracis 575/122 R00
5.
B. anthracis 81/1 R00B. anthracis 575/122 R00
(штамм продуцент)
белок Sap
белок ЕА1
6.
Фенотипические свойства бесплазмидныхвариантов B. anthracis
B. anthracis 575/122 R00
B. anthracis 81/1 R00
Рост колоний на сердечно-мозговом агаре
B. anthracis 81/1 R00
B. anthracis 575/122 R00
Рост колоний на триптиказо-соевом агаре
7.
B. anthracis 575/122 R00B. anthracis 81/1 R00
Рост колоний на кровяном агаре
8.
Электрофорез белков КФ B. anthracis.1 - B. anthracis 81/1 R00 (рХО1-, рХО2-);
2 - B. anthracis 575/122 R00 (рХО1-, рХО2-)
Иммуноблоттинг белков КФ с сывороткой
к КФ B. anthracis СТИ.
Культуральные фильтраты:
B. anthracis 81/1 R00 (рХО1-, рХО2-).
9.
Дефект штамма B. anthracis 81/1 R00в генах, кодирующие белки S-слоя
10.
Схема исследованияhttps://www.google.com/Fbiomolecula.ru
3.
Высокопроизводительное
секвенирование
1. Выделение гДНК
B. anthracis
https://www.google.com/helicon.ru
2. Создание библиотек
4. Демультиплексирование
6. Анализ данных
5. Триммирование ридов
11.
Сравнительный анализ рефесного штаммаB. anthracis Ames с полученными сборками
По гену sap
B. anthracis 81/1 R00
B. anthracis 575/122 R00
12.
По гену eagB. anthracis 81/1 R00
B. anthracis 575/122 R00
13.
B. anthracis 81/1 R00B. anthracis 575/122 R00
bclB
rpoB; murF;
pflB; tenI
divC; rplL
prsA; pepF
murF; pflB;
tenI; hmoA
cydC
hemH; lepB

medicine
medicine biology
biology








